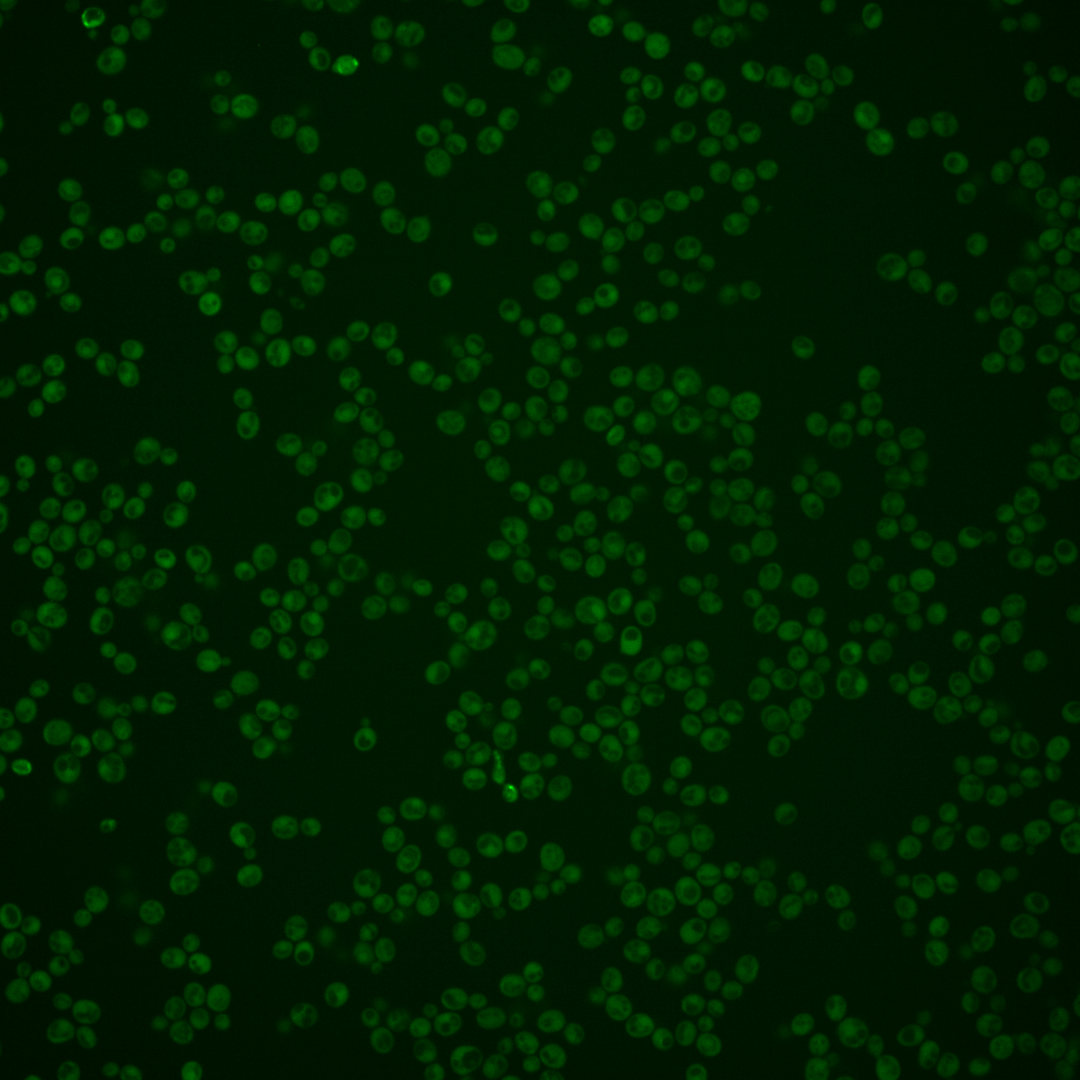
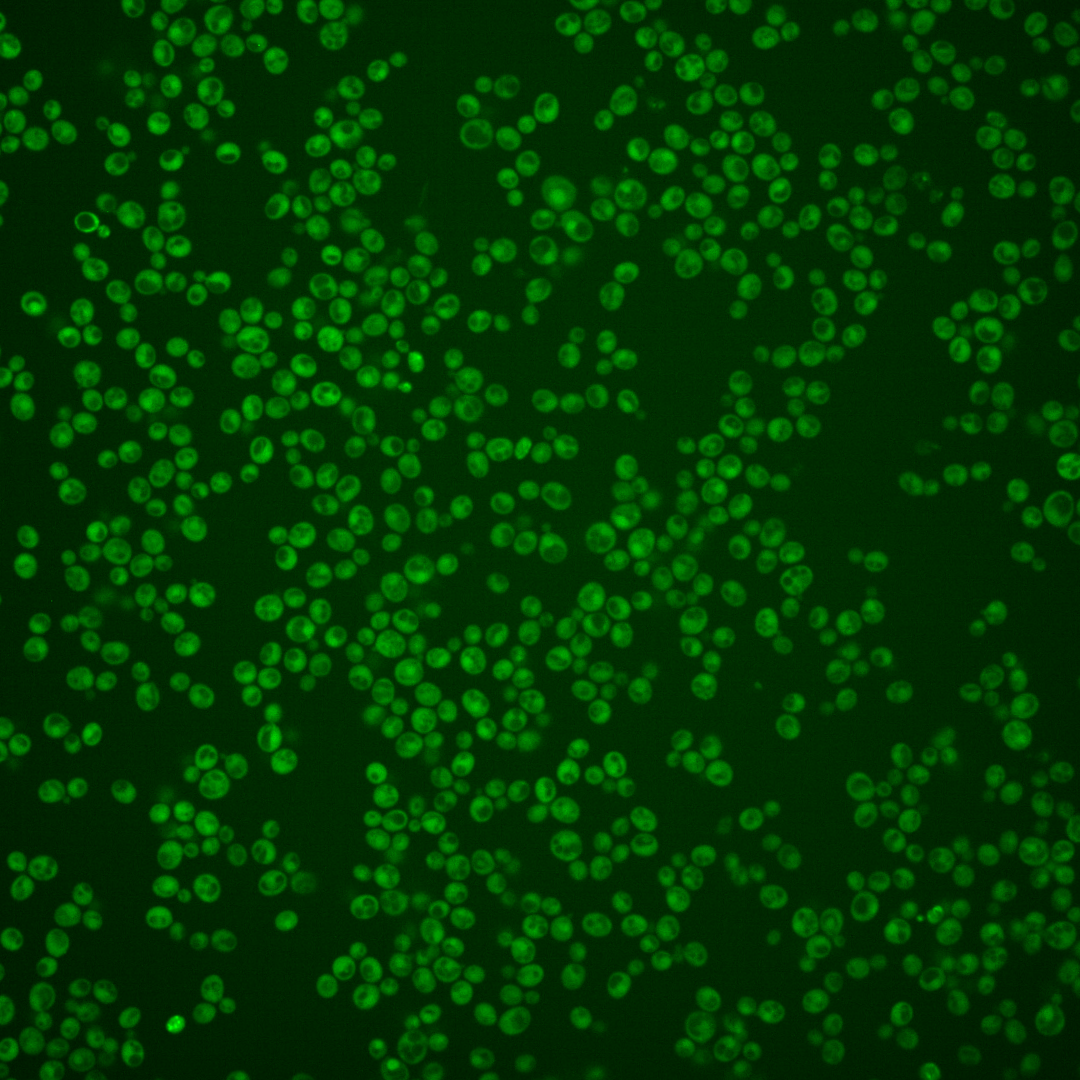
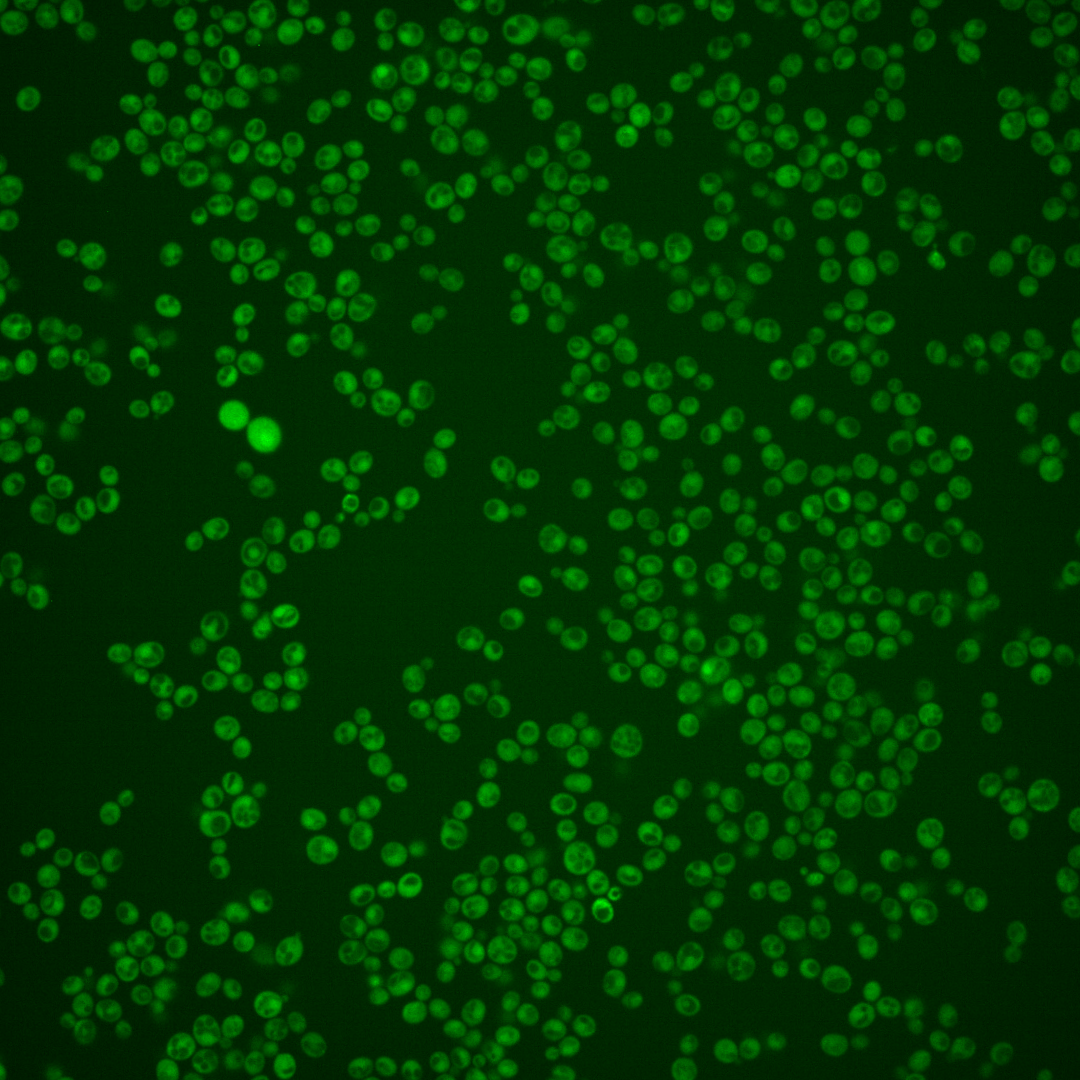
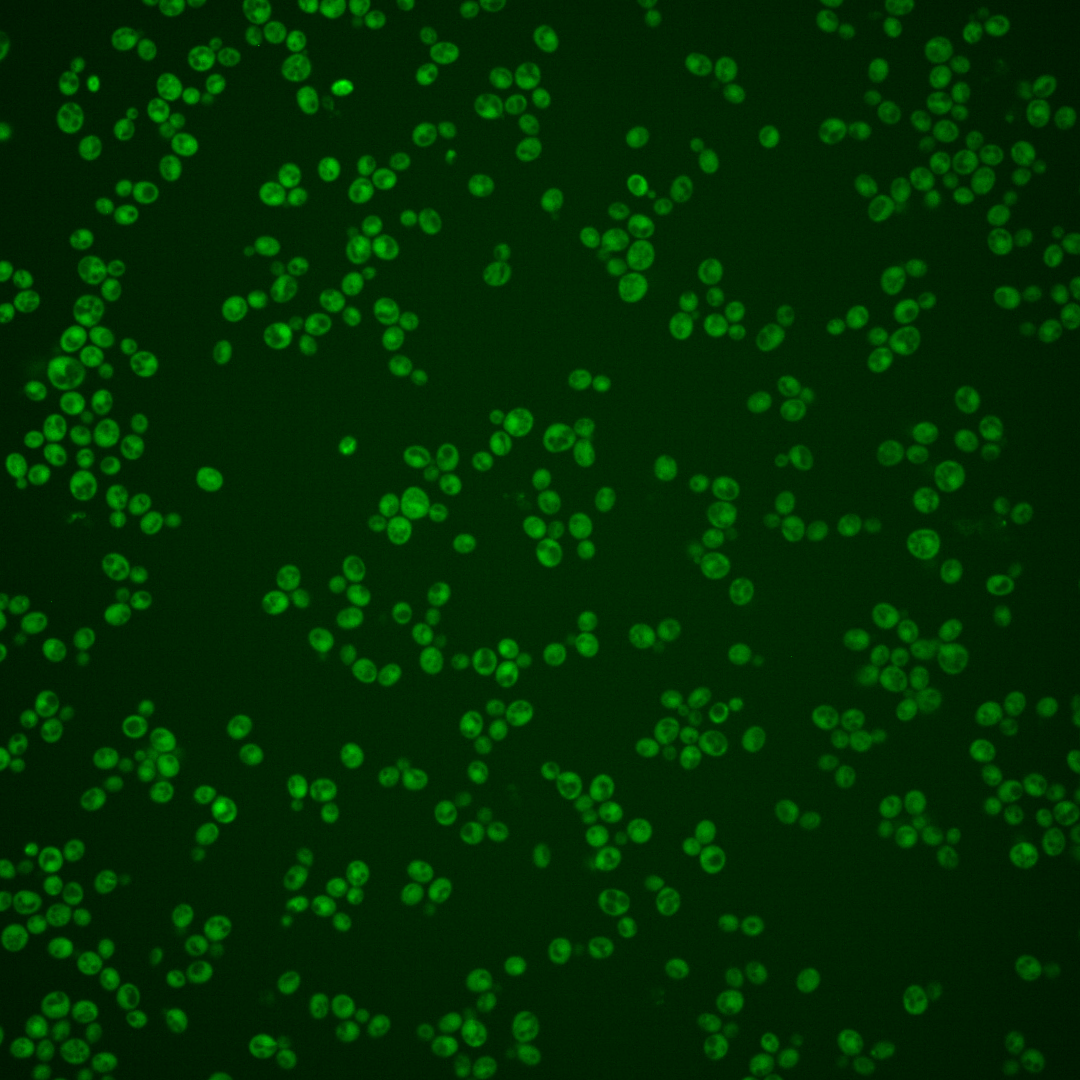
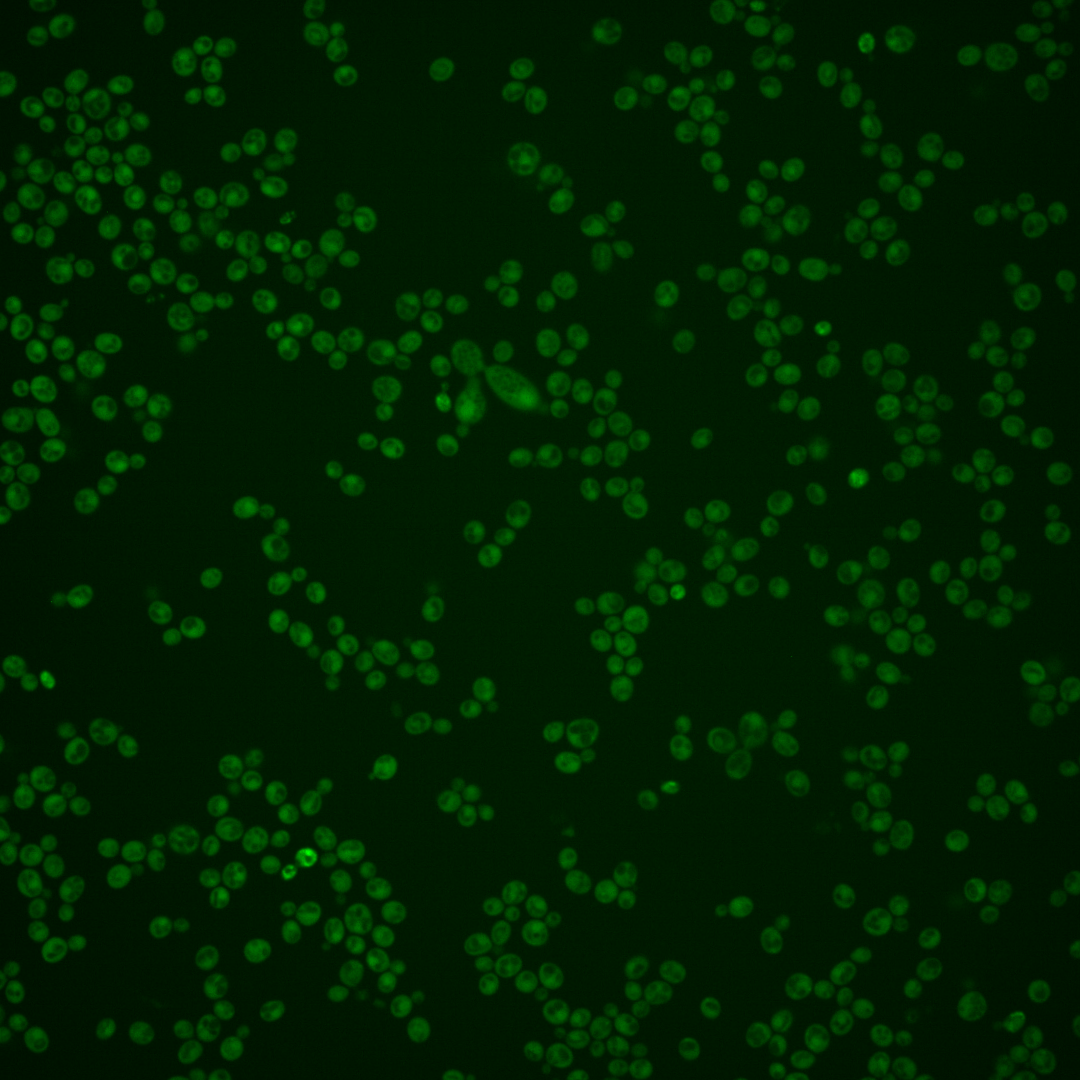

| Standard name | |
|---|---|
| Human Ortholog | |
| Description | Cytoplasmic aldehyde dehydrogenase; involved in ethanol oxidation and beta-alanine biosynthesis; uses NAD+ as the preferred coenzyme; expression is stress induced and glucose repressed; very similar to Ald3p |
Micrographs




















































































Sub-cellular Localization
Yeast GFP Assignment
Protein Abundance
Localization Change
External localization resources
| ensLOC | DeepLoc | |||||||||||||||||||||||
|---|---|---|---|---|---|---|---|---|---|---|---|---|---|---|---|---|---|---|---|---|---|---|---|---|
| Localization | WT1 | WT2 | WT3 | RAP60 | RAP140 | RAP220 | RAP300 | RAP380 | RAP460 | RAP540 | RAP620 | RAP700 | HU80 | HU120 | HU160 | rpd3Δ_1 | rpd3Δ_2 | rpd3Δ_3 | WT1 | WT2 | WT3 | AF100 | AF140 | AF180 |
| Cortical Patches | 0 | 0 | 0 | 0 | 0 | 1 | 1 | 8 | 4 | 5 | 4 | 5 | 0 | 0 | 0 | 0 | 0 | 0 | 0 | 0 | 0 | 0 | 0 | 1 |
| Bud | 0 | 1 | 3 | 1 | 0 | 0 | 1 | 0 | 3 | 2 | 2 | 4 | 3 | 0 | 0 | 0 | 0 | 0 | 0 | 1 | 0 | 0 | 5 | 9 |
| Bud Neck | 0 | 0 | 0 | 0 | 0 | 0 | 0 | 0 | 0 | 0 | 0 | 0 | 0 | 0 | 0 | 0 | 0 | 0 | 0 | 0 | 0 | 0 | 0 | 1 |
| Bud Site | 0 | 0 | 0 | 0 | 0 | 0 | 0 | 0 | 0 | 0 | 0 | 0 | 0 | 0 | 0 | 0 | 0 | 0 | – | – | – | – | – | – |
| Cell Periphery | 0 | 0 | 0 | 0 | 3 | 10 | 6 | 15 | 16 | 24 | 9 | 36 | 1 | 0 | 1 | 7 | 8 | 1 | 0 | 0 | 0 | 0 | 0 | 0 |
| Cytoplasm | 68 | 281 | 132 | 140 | 151 | 250 | 213 | 282 | 200 | 213 | 170 | 262 | 271 | 308 | 358 | 426 | 279 | 210 | 85 | 276 | 126 | 141 | 256 | 225 |
| Endoplasmic Reticulum | 1 | 1 | 1 | 0 | 2 | 7 | 9 | 21 | 15 | 24 | 8 | 11 | 0 | 1 | 0 | 14 | 7 | 5 | 0 | 0 | 1 | 0 | 2 | 0 |
| Endosome | 0 | 0 | 0 | 0 | 0 | 0 | 2 | 0 | 0 | 0 | 0 | 0 | 0 | 0 | 0 | 3 | 2 | 2 | 0 | 1 | 1 | 0 | 1 | 0 |
| Golgi | 0 | 1 | 0 | 0 | 0 | 1 | 1 | 0 | 0 | 0 | 0 | 0 | 1 | 0 | 0 | 1 | 1 | 0 | 0 | 0 | 0 | 1 | 0 | 1 |
| Mitochondria | 4 | 6 | 6 | 6 | 2 | 14 | 18 | 22 | 35 | 48 | 49 | 90 | 1 | 1 | 0 | 9 | 0 | 0 | 0 | 4 | 1 | 0 | 1 | 6 |
| Nucleus | 0 | 1 | 0 | 0 | 0 | 0 | 2 | 3 | 1 | 2 | 3 | 2 | 0 | 0 | 0 | 5 | 0 | 1 | 0 | 0 | 0 | 0 | 0 | 0 |
| Nuclear Periphery | 1 | 0 | 0 | 0 | 0 | 0 | 0 | 0 | 0 | 2 | 0 | 0 | 0 | 0 | 0 | 0 | 0 | 0 | 0 | 0 | 0 | 0 | 0 | 0 |
| Nucleolus | 0 | 0 | 0 | 0 | 0 | 0 | 0 | 0 | 1 | 0 | 0 | 1 | 0 | 0 | 0 | 0 | 0 | 0 | 0 | 0 | 0 | 0 | 0 | 0 |
| Peroxisomes | 0 | 0 | 0 | 0 | 0 | 0 | 0 | 0 | 0 | 0 | 0 | 0 | 0 | 0 | 0 | 0 | 0 | 0 | 0 | 0 | 0 | 0 | 0 | 0 |
| SpindlePole | 0 | 0 | 0 | 0 | 0 | 0 | 0 | 0 | 0 | 0 | 0 | 0 | 0 | 0 | 0 | 0 | 0 | 0 | 0 | 1 | 1 | 0 | 3 | 1 |
| Vac/Vac Membrane | 0 | 0 | 1 | 0 | 5 | 4 | 22 | 36 | 11 | 24 | 16 | 22 | 3 | 2 | 1 | 10 | 11 | 2 | 0 | 2 | 1 | 0 | 0 | 4 |
| Unique Cell Count | 72 | 288 | 137 | 141 | 159 | 272 | 259 | 362 | 257 | 297 | 235 | 382 | 275 | 309 | 358 | 443 | 288 | 214 | 90 | 291 | 136 | 150 | 275 | 259 |
| Labelled Cell Count | 74 | 291 | 143 | 147 | 163 | 287 | 275 | 387 | 286 | 344 | 261 | 433 | 280 | 312 | 360 | 475 | 308 | 221 | 90 | 291 | 136 | 150 | 275 | 259 |
Yeast GFP Assignment
Protein Abundance
| Screen | WT1 | WT2 | WT3 | RAP60 | RAP140 | RAP220 | RAP300 | RAP380 | RAP460 | RAP540 | RAP620 | RAP700 | HU80 | HU120 | HU160 | rpd3Δ_1 | rpd3Δ_2 | rpd3Δ_3 | AF100 | AF140 | AF180 |
|---|---|---|---|---|---|---|---|---|---|---|---|---|---|---|---|---|---|---|---|---|---|
| Mean Cell GFP Intensity (1e-4) | 4.3 | 5.2 | 4.7 | 5.4 | 11.9 | 14.0 | 13.0 | 14.1 | 13.6 | 11.9 | 12.0 | 11.7 | 5.7 | 5.7 | 5.9 | 8.9 | 10.4 | 11.8 | 5.3 | 5.6 | 6.5 |
| Std Deviation (1e-4) | 1.0 | 1.0 | 1.0 | 1.3 | 4.2 | 5.2 | 4.7 | 5.0 | 4.6 | 4.2 | 4.6 | 4.2 | 1.2 | 1.3 | 1.6 | 3.1 | 2.7 | 5.1 | 1.2 | 2.1 | 1.9 |
| Intensity Change (Log2) | – | – | – | 0.19 | 1.34 | 1.57 | 1.47 | 1.59 | 1.54 | 1.34 | 1.36 | 1.32 | 0.28 | 0.28 | 0.34 | 0.92 | 1.15 | 1.33 | 0.18 | 0.25 | 0.46 |
Localization Change
| Localization | RAP60 | RAP140 | RAP220 | RAP300 | RAP380 | RAP460 | RAP540 | RAP620 | RAP700 | HU80 | HU120 | HU160 | rpd3Δ_1 | rpd3Δ_2 | rpd3Δ_3 |
|---|---|---|---|---|---|---|---|---|---|---|---|---|---|---|---|
| Cortical Patches | 0 | 0 | 0 | 0 | 0 | 0 | 0 | 0 | 0 | 0 | 0 | 0 | 0 | 0 | 0 |
| Bud | 0 | 0 | 0 | 0 | 0 | 0 | 0 | 0 | 0 | 0 | 0 | 0 | 0 | 0 | 0 |
| Bud Neck | 0 | 0 | 0 | 0 | 0 | 0 | 0 | 0 | 0 | 0 | 0 | 0 | 0 | 0 | 0 |
| Bud Site | 0 | 0 | 0 | 0 | 0 | 0 | 0 | 0 | 0 | 0 | 0 | 0 | 0 | 0 | 0 |
| Cell Periphery | 0 | 0 | 0 | 0 | 0 | 3.0 | 3.4 | 0 | 3.7 | 0 | 0 | 0 | 0 | 0 | 0 |
| Cytoplasm | 1.7 | -0.6 | -1.7 | -4.0 | -4.9 | -4.8 | -5.9 | -5.7 | -6.5 | 1.4 | 2.8 | 3.6 | -0.1 | 0.3 | 1.0 |
| Endoplasmic Reticulum | 0 | 0 | 0 | 0 | 2.5 | 2.4 | 3.1 | 0 | 0 | 0 | 0 | 0 | 0 | 0 | 0 |
| Endosome | 0 | 0 | 0 | 0 | 0 | 0 | 0 | 0 | 0 | 0 | 0 | 0 | 0 | 0 | 0 |
| Golgi | 0 | 0 | 0 | 0 | 0 | 0 | 0 | 0 | 0 | 0 | 0 | 0 | 0 | 0 | 0 |
| Mitochondria | -0.1 | 0 | 0.3 | 1.0 | 0.7 | 2.9 | 3.5 | 4.3 | 5.0 | 0 | 0 | 0 | 0 | 0 | 0 |
| Nucleus | 0 | 0 | 0 | 0 | 0 | 0 | 0 | 0 | 0 | 0 | 0 | 0 | 0 | 0 | 0 |
| Nuclear Periphery | 0 | 0 | 0 | 0 | 0 | 0 | 0 | 0 | 0 | 0 | 0 | 0 | 0 | 0 | 0 |
| Nucleolus | 0 | 0 | 0 | 0 | 0 | 0 | 0 | 0 | 0 | 0 | 0 | 0 | 0 | 0 | 0 |
| Peroxisomes | 0 | 0 | 0 | 0 | 0 | 0 | 0 | 0 | 0 | 0 | 0 | 0 | 0 | 0 | 0 |
| SpindlePole | 0 | 0 | 0 | 0 | 0 | 0 | 0 | 0 | 0 | 0 | 0 | 0 | 0 | 0 | 0 |
| Vacuole | 0 | 0 | 0 | 3.1 | 3.5 | 0 | 3.1 | 2.7 | 2.5 | 0 | 0 | 0 | 0 | 0 | 0 |
External localization resources
Images






























Protein Concentration and Protein Localization Data
| R1 | R2 | R3 | ||||||||||||||||
|---|---|---|---|---|---|---|---|---|---|---|---|---|---|---|---|---|---|---|
| G1 Pre-START | G1 Post-START | S/G2 | Metaphase | Anaphase | Telophase | G1 Pre-START | G1 Post-START | S/G2 | Metaphase | Anaphase | Telophase | G1 Pre-START | G1 Post-START | S/G2 | Metaphase | Anaphase | Telophase | |
| Concentration | – | – | – | – | – | – | – | – | – | – | – | – | – | – | – | – | – | – |
| Actin | 0.1312 | 0.0003 | 0.0238 | 0.0003 | 0.01 | 0.0034 | 0.0237 | 0.0011 | 0.0141 | 0.0071 | 0.0084 | 0.0096 | 0.0105 | 0.0003 | 0.0022 | 0.0004 | 0.0148 | 0.0002 |
| Bud | 0.0011 | 0.0001 | 0.0004 | 0.0001 | 0.0012 | 0.0028 | 0.0019 | 0.0033 | 0.0002 | 0.0014 | 0.0007 | 0.0005 | 0.0028 | 0.0042 | 0.0002 | 0.0001 | 0.0015 | 0.0001 |
| Bud Neck | 0.0008 | 0.0001 | 0.0006 | 0.0003 | 0.0012 | 0.0009 | 0.0007 | 0.0002 | 0.0003 | 0.0023 | 0.0004 | 0.0005 | 0.004 | 0.0003 | 0.0046 | 0.0002 | 0.0008 | 0.0002 |
| Bud Periphery | 0.001 | 0 | 0.0006 | 0.0001 | 0.0018 | 0.0071 | 0.0024 | 0.0045 | 0.0002 | 0.0017 | 0.0008 | 0.0008 | 0.0044 | 0.0006 | 0.0002 | 0.0001 | 0.0015 | 0 |
| Bud Site | 0.0054 | 0.0004 | 0.002 | 0.0001 | 0.0024 | 0.0015 | 0.0097 | 0.0094 | 0.0019 | 0.001 | 0.0002 | 0.0002 | 0.0259 | 0.0068 | 0.006 | 0.0001 | 0.0047 | 0 |
| Cell Periphery | 0.0003 | 0.0004 | 0.0006 | 0 | 0.0008 | 0.0001 | 0.0005 | 0.0001 | 0.0001 | 0.0003 | 0 | 0 | 0.0032 | 0.0005 | 0.0003 | 0 | 0.0003 | 0 |
| Cytoplasm | 0.0305 | 0.6899 | 0.5281 | 0.6181 | 0.5326 | 0.6325 | 0.3221 | 0.5326 | 0.481 | 0.4427 | 0.5522 | 0.4702 | 0.27 | 0.6523 | 0.4608 | 0.6546 | 0.6299 | 0.5138 |
| Cytoplasmic Foci | 0.183 | 0.0039 | 0.0159 | 0.0034 | 0.0224 | 0.0113 | 0.0291 | 0.0054 | 0.0149 | 0.0118 | 0.016 | 0.0098 | 0.0681 | 0.0445 | 0.0057 | 0.0032 | 0.0295 | 0.0024 |
| Eisosomes | 0.0007 | 0.0001 | 0.0005 | 0 | 0.0002 | 0.0001 | 0.0004 | 0 | 0.0002 | 0.0001 | 0.0001 | 0.0001 | 0.0004 | 0.0001 | 0.0003 | 0 | 0.0001 | 0 |
| Endoplasmic Reticulum | 0.0184 | 0.0039 | 0.012 | 0.0014 | 0.0063 | 0.0028 | 0.0029 | 0.0009 | 0.0024 | 0.0018 | 0.0019 | 0.001 | 0.0048 | 0.0021 | 0.0018 | 0.0011 | 0.0142 | 0.0006 |
| Endosome | 0.2332 | 0.0017 | 0.0183 | 0.0012 | 0.0078 | 0.0063 | 0.0172 | 0.001 | 0.0094 | 0.0035 | 0.0052 | 0.0042 | 0.0333 | 0.0006 | 0.0032 | 0.0008 | 0.0456 | 0.0004 |
| Golgi | 0.063 | 0.0001 | 0.0093 | 0.0001 | 0.0033 | 0.0008 | 0.0109 | 0.0007 | 0.006 | 0.0009 | 0.0009 | 0.0017 | 0.0064 | 0.0001 | 0.0007 | 0.0001 | 0.0126 | 0 |
| Lipid Particles | 0.1479 | 0.0001 | 0.0083 | 0.0001 | 0.0009 | 0.0007 | 0.0141 | 0.0001 | 0.0042 | 0.0003 | 0.0002 | 0.0013 | 0.033 | 0.0003 | 0.0026 | 0 | 0.0087 | 0 |
| Mitochondria | 0.0092 | 0.0001 | 0.0118 | 0.0001 | 0.0034 | 0.0006 | 0.0049 | 0.0003 | 0.002 | 0.0006 | 0.0005 | 0.0019 | 0.0031 | 0.0025 | 0.0003 | 0.0002 | 0.0034 | 0 |
| None | 0.031 | 0.2951 | 0.3536 | 0.3707 | 0.4013 | 0.3212 | 0.5104 | 0.4366 | 0.4331 | 0.51 | 0.4063 | 0.4916 | 0.4188 | 0.2777 | 0.4983 | 0.336 | 0.2045 | 0.4805 |
| Nuclear Periphery | 0.0148 | 0.001 | 0.0037 | 0.0005 | 0.0005 | 0.0012 | 0.003 | 0.0003 | 0.001 | 0.0021 | 0.0006 | 0.0009 | 0.0016 | 0.0004 | 0.0008 | 0.0005 | 0.0036 | 0.0002 |
| Nucleolus | 0.0009 | 0 | 0.0003 | 0 | 0.0001 | 0.0003 | 0.0035 | 0.0001 | 0.0002 | 0.0003 | 0.0001 | 0.0001 | 0.0147 | 0.0015 | 0.003 | 0 | 0.0003 | 0 |
| Nucleus | 0.002 | 0.0012 | 0.0017 | 0.0023 | 0.0007 | 0.0022 | 0.0089 | 0.0014 | 0.0057 | 0.0038 | 0.0017 | 0.0015 | 0.0091 | 0.0018 | 0.0034 | 0.0019 | 0.0018 | 0.0008 |
| Peroxisomes | 0.0875 | 0 | 0.0011 | 0.0001 | 0.002 | 0.0006 | 0.0249 | 0.0008 | 0.0204 | 0.0004 | 0.002 | 0.0016 | 0.0513 | 0.0002 | 0.0009 | 0.0001 | 0.0127 | 0 |
| Punctate Nuclear | 0.0336 | 0.0003 | 0.0011 | 0.0004 | 0.0005 | 0.0021 | 0.0062 | 0.0004 | 0.0016 | 0.0058 | 0.0012 | 0.0019 | 0.0092 | 0.002 | 0.0039 | 0.0003 | 0.007 | 0.0002 |
| Vacuole | 0.0026 | 0.001 | 0.0055 | 0.0006 | 0.0007 | 0.0015 | 0.0021 | 0.0006 | 0.0008 | 0.0015 | 0.0006 | 0.0005 | 0.0238 | 0.0012 | 0.0009 | 0.0004 | 0.0019 | 0.0002 |
| Vacuole Periphery | 0.0021 | 0.0001 | 0.0009 | 0.0001 | 0.0002 | 0.0002 | 0.0004 | 0.0001 | 0.0002 | 0.0003 | 0.0001 | 0.0002 | 0.0014 | 0.0002 | 0.0001 | 0.0001 | 0.0006 | 0 |
Sequencing Data
| R1 | R2 | |||||||||
|---|---|---|---|---|---|---|---|---|---|---|
| G1 Post-START | S/G2 | Metaphase | Anaphase | Telophase | G1 Post-START | S/G2 | Metaphase | Anaphase | Telophase | |
| Gene Expression | 14.1462 | 16.2126 | 15.399 | 14.0452 | 9.876 | 14.5009 | 14.4255 | 13.4979 | 20.4444 | 16.2759 |
| Translational Efficiency | 1.0067 | 0.7554 | 0.6796 | 0.8645 | 1.2974 | 0.944 | 1.104 | 1.1756 | 0.7951 | 0.9245 |
Hit Data
| Dataset | Hit |
|---|---|
| Protein Concentration | – |
| Protein Localization | ✘ |
| Gene Expression | ✘ |
| Translational Efficiency | ✘ |
Endocytosis
| Temp | Actin Patch (Sac6-tdTomato) | Cortical Patch (Sla1-GFP) | Late Endosome (Snf7-GFP) | Vacuole (Vph1-GFP) |
|---|---|---|---|---|
| 37℃ | ||||
| RT |
Cell Cycle Omics
CYCLoPs (Ald2-GFP)
| Gene / Allele | Actin Patch (Sac6-tdTomato) | Cortical Patch (Sla1-GFP) | Late Endosome (Snf7-GFP) | Vacuole (Sac6-tdTomato) |
|---|
| Gene | Images |
|---|
| Gene | Images |
|---|
Images are not yet available
Images are not yet available